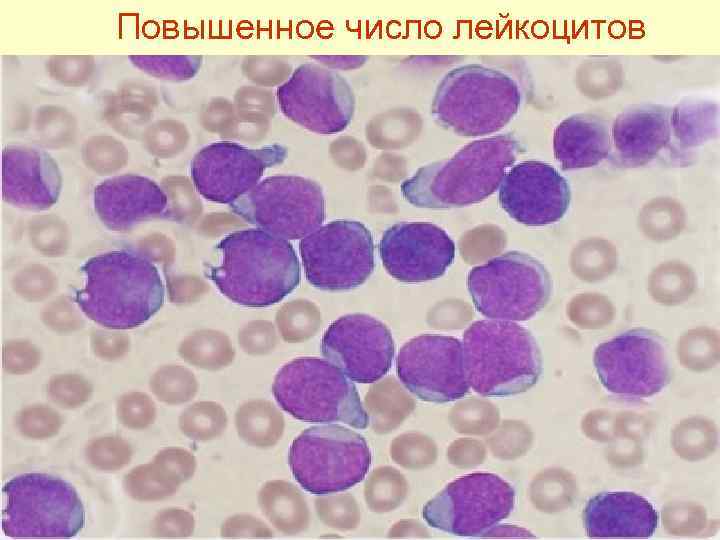
Повышенное число лейкоцитов

д. в. н. профессор Касымов Е. И.

д. в. н. профессор Касымов Е. И.
Лейкоз крупного рогатого скота (лат. – Bovine leucosis; англ. – Leukaemia in cattle; гемобластоз, энзоотический лейкоз, хроническая инфекционная болезнь опухолевой природы) – хроническая болезнь опухолевой природы, протекающая бессимптомно или характеризующаяся лимфоцитозом и злокачественным разрастанием кроветворных и лимфоидных клеток в различных органах.
ИСТОРИЧЕСКАЯ СПРАВКА. Начало учения о лейкозе связано с именем Рудольфа Вирхова, известного немецкого морфолога, который в 1845 г. впервые описал болезнь у человека и выделил ее в самостоятельную нозологическую единицу под названием "лейкемия".
Первый случай лейкемии у животных описал патологоанатом Дрезденского ветеринарного института Лейзеринг (Leisering) в 1858 году. О. Зидамгродский (О. Siedamgrotzki) в 1871 г. сделал сообщение о лейкозе у свиней и собак, а в 1878 г. он же впервые описал лейкоз у крупного рогатого скота. К настоящему времени лейкозы диагностированы как у теплокровных, так и холоднокровных животных. В разное время эту болезнь называли белокровием, лейкемией, раком крови, лейкозом и др.
В. Эллерман в 1921 г. предложил заменить название болезни "Лейкемия" термином "Лейкоз", который более полно характеризовал патологический процесс, развивающийся в кроветворной ткани, независимо от изменений, наблюдаемых в периферической крови. В 1953 г. Х. Х. Владос, Н. А. Краевский и другие исследователи предложили новое название болезни "гемобластозы", так как при лейкозе наблюдали гиперплазию клеток кроветворной и лимфоидной тканей с развитием злокачественных опухолей. Несмотря на обоснованность термина "гемобластозы", в нашей стране более принято употреблять термин "Лейкоз".
Классификация гемобластозов. До настоящего времени пока еще нет совершенной классификации опухолевых болезней кроветворной ткани у животных. В соответствии с методическими указаниями по диагностике лейкоза крупного рогатого скота, в зависимости от характера распространения опухолевых клеток лейкоз классифицируют на две группы опухолей - системные и опухолевые.
Первая отличается системностью поражения кроветворной и лимфоидной тканей с вовлечением в процесс костного мозга, селезенки, лимфатических узлов и включает: лимфоидный, миелоидный лейкозы и злокачественный гистиоцитоз. Болезни второй группы; лимфосаркома, плазмоцитома, ретикулосаркома и лимфогранулематоз характеризуются первичным поражением лимфоидной ткани (лимфатические узлы, селезенка).
Опухоли, состоящие из клеточных элементов, природу которых пока трудно установить, относят к числу недифференцированных лейкозов, или недифференцированных лимфом. Вирусогенетическая теория происхождения злокачественных опухолей Л. А. Зильбера в настоящее время доминирующая; она подтверждается результатами исследования лейкозов крупного рогатого скота. В настоящее время лейкоз крупного рогатого скота объединяет опухолевые болезни кроветворных органов, а также лимфоидный, миелоидный и слабодифференцированный (гемоцитобластоз) лейкозы, лимфосаркому, ретикулосаркому, лимфогрануломатоз.
Лимфосаркома
Лимфосаркома
Лимфосаркома
Лимфосаркома
Лимфосаркома
Ретикулосаркома
Лимфогрануломатоз
Возбудитель болезни у КРС Вирус лейкоза крупного рогатого скота – РНК-содержащий вирус подсемейства Oncornavirinae (опухолевые вирусы) семейства Retroviridae. Основным признаком всех представителей семейства Retroviridae является наличие в вирионе обратной транскриптазы. В состав подсемейства Oncornavirinae входят три рода, дифференцируемые на основании морфологии вирионов: вирусы типов С, В и D.
Вирусы типа С делят на два подрода: вирусы типа С млекопитающих и вирус лейкоза крупного рогатого скота (ВЛКРС). ВЛКРС – это экзогенный вирус в отношении крупного рогатого скота и других чувствительных видов животных. Репликация вируса ограничивается клетками лимфоидной популяции и не выявлена в других тканях организма.
Установлено, что ВЛКРС чувствителен к температурным воздействиям, разрушается при повторяющихся замораживаниях и оттаиваниях и прогревании при 56°С в течение 15 мин. Пастеризация молока (74°С в течение 16 с) разрушает ВЛКРС. Полная инактивация вируса в молоке или вируссодержащей жидкости (кровь, молозиво) установлена при 50°С в течение 70 с, при 70 -74°С – за 17 с.
Прямой солнечный свет инактивирует ВЛКРС в течение 4 ч, УФ-лучи – в течение 30 мин. Вирус полностью теряет активность в 2%-ных растворах гидроксида натрия и формальдегида и других дезинфектантов в общепринятых концентрациях.
Таким образом, решающее этиологическое значение ВЛКРС при возникновении гемобластозов крупного рогатого скота доказано. Вместе с тем при изучении вирусной этиологии опухолей и лейкозов животных накапливались достоверные данные о том, что канцерогенный эффект вирусов проявляется в зависимости от иммунобиологического состояния организма и воздействия стресс-факторов. Отмечается также более выраженная генетическая устойчивость отдельных пород и линий животных к ВЛКРС.
ЭПИЗООТОЛОГИЧЕСКИЕ ДАННЫЕ. Лейкозы наиболее распространены среди крупного рогатого скота. Болезнь диагностируют на всех континентах мира. Наиболее широко она распространена в Германии, Польше и США. Отмечена неравномерность поражения животных в отдельных странах и хозяйствах.
Лейкозом болеют как молодые, так и взрослые животные всех разводимых пород и их помеси, но чаще он отмечается у животных 4— 8 -летнего возраста. Болезнь обычно наблюдают среди скота красной и черно-пестрой пород. К лейкозу крупного рогатого скота восприимчивы также овцы и козы. Эпидемиологическими и эпизоотологическими исследованиями не установлена связь между заболеваниями лейкозом человека и животных.
Источником возбудителя лейкоза является больное животное. Уже на ранних стадиях болезни онкорнавирус выделяется из организма коров с молозивом и молоком. Имеются сведения о возможном выделении возбудителя со слюной. Внутри стад возможны вертикальный (через плаценту, молозиво и молоко) и горизонтальный механизмы передачи возбудителя, однако конгенитальное заражение происходит сравнительно редко.
Телята заражаются главным образом постнатально. Значение кровососущих насекомых, инфицированных предметов и других факторов в механизме передачи возбудителя лейкоза требует экспериментального подтверждения. Передачи вируса через сперму, по- видимому, не происходит.
Основным естественным фактором передачи ВЛКРС считается молоко инфицированных и особенно больных на клинико-гематологических и опухолевых стадиях коров. Учитывая возможность переноса ВЛКРС ничтожным количеством крови, следует иметь в виду, что при несоблюдении правил асептики и антисептики болезнь может распространиться во время проведения ветеринарных и зоотехнических процедур (ятрогенный фактор передачи): ректальные исследования, фиксация за носовые перегородки, бонитировка, массовые вакцинации, взятия крови, проведение хирургических операций и т. п.
По интенсивности развития эпизоотического процесса гемобластозы крупного рогатого скота относятся к медленно развивающимся инфекционным болезням. Контагиозность лейкоза незначительна. Сезонность не проявляется. Природно- географические и климатические факторы не влияют на распространение болезни.
У некоторых, чаще всего взрослых животных, несущих наследственную предрасположенность, при дополнительных молекулярно- биологических и иммунобиологических перестройках в клетке болезнь проявляется гематологическими и реже опухолевыми изменениями в органах кроветворения.
ПАТОГЕНЕЗ лейкоза крупного рогатого скота определяется взаимоотношением вируса и клетки. Болезнь чаще протекает в латентной форме. Под влиянием различных экзогенных и эндогенных факторов происходит активация возбудителя, проявляющаяся у отдельных животных медленным расстройством регуляторной функции органов кроветворения. Основным признаком лейкоза является нарушение нормального процесса пролиферации и дифференциации клеток кроветворной ткани.
Чаще поражаются лейкобластические клетки, что приводит к интенсивной пролиферации различных типов лейкоцитов в кроветворных органах, в костном мозге, селезенке, лимфоузлах. Неконтролируемо селезенке, лимфоузлах. размножающиеся клетки крови распространяются по организму и попадают в различные органы и ткани, образуют опухоли, вызывающие изменение структуры и функции пораженных органов вследствие атрофии специфических клеток. Появляются нарушения на молекулярном, клеточном и органном уровнях, что приводит к расстройству кроветворения, увеличению количества лимфоцитов.
Течение и клиническое проявление болезни у КРС. Лейкозы характеризуются длительным латентным периодом (инкубационный период), во время которого в крови выявляют ВЛКРС и антитела к нему. При спонтанном заражении этот период длится от 2 до 6 лет. Клинические проявления зависят от вовлечения в патологический процесс органов – лимфатических узлов, селезенки, сычуга, сердца, почек, половых и др.
Инфекционный процесс при лейкозе развивается медленно и незаметно. В развитии лейкозного процесса у крупного рогатого скота различают четыре стадии: • предлейкозную; • начальную (доклиническую); • развернутую (клинико-гематологическую); • конечную, или терминальную (опухолевую).
Предлейкозная стадия у Предлейкозная стадия зараженных ВЛКРС животных проявляется в виде относительного лимфоцитоза (до 14 тыс/мкл) за счет лимфоидных клеток, характерных для подозрительных по заболеванию по «лейкозному ключу» . Обнаружить другие патологические изменения не удается.
Умеренное увеличение числа лимфоцитов в крови
Начальная стадия характеризуется отсутствием клинических признаков болезни, но более постоянными изменениями количественного и качественного состава крови. Число лейкоцитов колеблется от 15 до 40 тыс/мкл, а среди лимфоцитов преобладают юные и средние клетки.
Резкое увеличение числа лимфоцитов в крови
Гематологические изменения могут многие годы оставаться стабильными. При этом общее состояние животного – упитанность, молочная продуктивность и воспроизводительная функция не вызывают подозрений на лейкоз. Лишь при обострении хронического течения болезни могут появляться такие признаки, как снижение удоя, истощение и другие, и лейкозный процесс переходит в развернутую стадию.
Развернутая стадия характеризуется Развернутая стадия кроме гематологических сдвигов разнообразием специфических и неспецифических клинических признаков. У животного ухудшается общее состояние, отмечаются быстрая утомляемость, плохой аппетит, снижаются удои, прогрессирует истощение, наблюдается атония преджелудков, сменяющаяся диареей.
Перкуссией нередко устанавливают увеличение сердца, число пульсовых ударов достигает до 120 в минуту, пульс слабого наполнения, волна малая. Сердечный толчок ослаблен. При сердечной слабости у животного развиваются отеки подкожной клетчатки в области подгрудка и межчелюстного пространства.
Специфическим клиническим признаком лейкозов крупного рогатого скота является прогрессирующее значительное увеличение поверхностных (околоушных, нижнечелюстных, заглоточных, предлопаточных, надвыменных и др. ) лимфатических узлов. Отмечается симметричное, но неравномерное увеличение их. Лимфатические узлы достигают величины от 5 до 20 см и более, они безболезненные, подвижные, эластичной или плотной консистенции.
У молодняка наряду с увеличением лимфатических узлов в области голодной ямки, поясницы, шеи, зобной железы часто отмечают опухолевидные разрастания, обусловливающие затрудненное дыхание. При значительном увеличении селезенки перкуссией устанавливают притуплённый или тупой звук, в некоторых случаях болезненность. Возможен разрыв селезенки, и животное внезапно погибает вследствие внутреннего кровоизлияния.
Увеличение предлопаточного лимфатического узла
Значительное увеличение некоторых лимфатических узлов, а также опухолевых разрастаний в тазовой и брюшной областях можно установить при ректальном исследовании. У некоторых (3 -5% случаев) больных лейкозами животных отмечают экзофтальм (пучеглазие).
Экзофтальм (пучеглазие).
Опухолевое разрастание в области грудной стенки
Терминальная (опухолевая) стадия лейкоза характеризуется дальнейшим развитием патологического процесса и более отчетливым проявлением клинических признаков: резким увеличением лимфатических узлов, которые могут заметно выступать на теле; отеками подкожной клетчатки в области подгрудка, межчелюстного пространства, конечностей. Это приводит к крайнему истощению органов кроветворения, блокаде иммунной системы и заканчивается смертью животного.
Увеличение лимфатических узлов, отек в области подгрудка
Увеличение лимфатических узлов, отек в области межчелюстного пространства
Увеличение лимфатического узла коленной складки, истощение.
У крупного рогатого скота может встречаться кожная форма лейкоза. На теле животного появляются узелковые припухлости диаметром до 2, 5 см, хорошо заметные на шее, спине, крестце и бедрах. В течение нескольких недель происходит облысение припухлости, ее поверхность покрывается корочкой, состоящей из эпителия и экссудата.
Кожная форма лейкоза
Затем корочки отпадают, а облысевшие участки вновь покрываются шерстью. Однако через несколько месяцев после кажущегося выздоровления наступает рецидив с появлением тех же признаков болезни. Происходит инфильтративное поражение висцеральных органов, и животное погибает.
Диагностика и дифференциальная диагностика болезни у КРС. Первичный диагноз в хозяйстве ставят на основании эпизоотологических, клинико- гематологических, серологических и патологоанатомических данных с обязательным проведением гистологического исследования.
Корову считают больной лейкозом при наличии одного из следующих показателей: 1) клинических признаков болезни; 2) положительных результатов гематологических исследований; 3) обнаружении у павшего (убитого) животного характерных патологоанатомических изменений; 4) установлении положительного результата гистологического исследования патологического материала в случае падежа (убоя) животных.
Клинические признаки проявляются, как правило, к концу болезни, поэтому в диагностике болезни они имеют лишь вспомогательное значение. Гематологическое исследование заключается в обнаружении в периферической крови повышенного числа лейкоцитов, в основном лимфоидного ряда, и слабодифференцированных клеток (родоначальных, пролимфоцитов, лимфобластов), а также полиморфных, атипичных клеток.
При гематологическом исследовании на лейкоз- используют различные критерии, названные лейкозными ключами. Определяют отклонения от нормальных количеств лейкоцитов и молодых клеток, абсолютное число и процентное отношение лимфоцитов.
Повышенное число лейкоцитов
Серологический метод диагностики основан на выявлении в сыворотке крови животных при помощи РИД антител к антигену ВЛКРС. Специфические антитела появляются в крови крупного рогатого скота через 2 мес после заражения, т. е. значительно раньше, чем гематологические изменения, и сохраняются пожизненно. РИД представляет собой основной метод серологического исследования животных в государственных программах по борьбе с лейкозом крупного рогатого скота во многих странах, в том числе в России.
НАБОР ДЛЯ ДИАГНОСТИКИ ЛЕЙКОЗА КРУПНОГО РОГАТОГО СКОТА В РЕАКЦИИ ИММУНОДИФФУЗИИ (РИД).
НАБОР ДЛЯ ВЫЯВЛЕНИЯ АНТИТЕЛ К ВИРУСУ ЛЕЙКОЗА КРУПНОГО РОГАТОГО СКОТА (ВЛКРС) МЕТОДОМ ИММУНОФЕРМЕНТНОГО АНАЛИЗА (ИФА)
При дифференциальной диагностике следует принимать во внимание ряд хронических инфекционных болезней крупного рогатого скота (актиномикоз, туберкулез, паратуберкулез, бруцеллез), а также некоторые незаразные болезни (гепатиты, циррозы, амилоидную дистрофию и другие болезни печени, маститы, пневмонии, ретикулоперикардиты, нефриты), сопровождающиеся лейкозоподобными изменениями гематологических показателей, называемых лейкемоидными реакциями.
ПАТОЛОГОАНАТОМИЧЕСКИЕ ИЗМЕНЕНИЯ. При вскрытии трупа в зависимости от формы и стадии течения лейкоза обнаруживают диффузную или очаговую инфильтрацию в органах кроветворения, на серозных покровах, в кишечнике, сердце, печени, почках, в матке и других органах.
Основными формами лейкоза являются собственно лейкозы и ретикулозы. К собственно лейкозам относят: лимфомиелолейкоз; гемобластоз, а ретикулозам — лимфо-, ретикуло-саркому, системный ретикулоз, лимфогранулематоз и плазмоцитому.
Эта классификации основана на патоморфологической характеристике разрастаний (новообразований), результатов цитологического и гематологического исследований циркулирующих в крови клеточных элементов (степени и созревания).
При исследовании трупов либо туш на мясокомбинатах обращают внимание на размеры органов, общее распространение опухолевых разрастаний, степень поражения лимфатических узлов. Необходимо учитывать, что при лимфолейкозе лимфатические узлы лимфолейкозе увеличены на одинаковую величину, не срастаются с окружающими тканями, капсула снимается легко, поверхность разреза серо-белая, состав узлов саловидный, сочный.
При лимфоидном лейкозе селезёнка увеличена в размерах в 3 -5 раз, гипер- плазированные фолликулы резко выступают, состав напоминает резину, часто капсулы увеличенного органа разрываются.
При лимфоидном лейкозе селезёнка увеличена в размерах, гиперплазированные фолликулы резко выступают,
Разрыв капсулы селезёнки
Разрыв селезёнки у коровы.
При лейкозе обнаруживают очаговые либо диффузные в виде опухоли разрастания серо-белого оттенка в паренхиме печени, почек, в толще сердечной мышцы, органах пищеварительного тракта, матке, скелетных мышцах и прочих органах.
Опухоли в паренхиме печени.
Опухоль в толще сердечной мышцы.
Опухоли серо-белого цвета в лёгких.
Опухоли серо-белого цвета в мускулатуре.
Опухоль на разрезе.
Лимфатические узлы при лимфогранулематозе, лимфосаркоме выделяются бугристостью, капсула сращена с паренхимой, при разрезе видны кровоизлияния и некрозы; в органах брюшной, тазовой полостей, на серозных оболочках обнаруживают опухолевидные наросты желтоватого цвета.
Опухоли на кишечнике.
Опухолевидные наросты желтоватого цвета на сердце
При миелолейкозе селезенка красно- малинового цвета, фолликулы едва заметны, состав органа рыхлый. При лимфосаркоме селезенка, как правило, в размерах не увеличена.
На гистологическое исследование при лейкозе отправляют кусочки при лейкозе (2 x 2 см) измененных органов - селезенки, лимфатических узлов, сердца, печени, легких, стенки пораженных органов пищеварения (очень часто сычуга), матки и скелетных мышц, фиксированных 10 %-ным р-ром формалина.
При лимфоидном лейкозе обнаруживают стирание свойственного строения органа вследствие бурной очаговой либо диффузной лимфоидно- клеточной инфильтрации. Среди клеток превалируют лимфоциты и в меньшем количестве пролимфоциты, лимфобласты.
Инфильтрация лимфоидными клетками ткани костного мозга.
Лимфоидные клетки между балками печени, в просвете сосуда обилие лимфоцитов.
Инфильтрация лимфоидными клетками ткани между канальцами и клубочками почки.
Лимфоидные клетки между волокнами миокарда
Нарушение структуры лимфатического узла за счет размножения однородных лимфоидных клеток.
Обильное размножение лимфоидных клеток в красной пульпе селезенки.
При миелолейкозе (встречается реже) в селезенке обнаруживают незрелые мегакариоциты, гематоцитобласты, а в лимфоузлах, печени, почках - очаговые либо диффузные разрастания миелоидных элементов.
ИММУНИТЕТ. Вопросы иммунитета и иммунизации при лейкозе мало изучены. В организме зараженных вирусом лейкоза животных с гематологическими и клиническими признаками болезни выявляют преци- питирующие и комплементсвязывающие антитела.
ПРОФИЛАКТИКА И МЕРЫ БОРЬБЫ Профилактика и меры борьбы с лейкозом в различных странах имеют свои особенности. В некоторых страна: существовала необычно жесткая система борьбы, предусматривающая убой всего стада, где выявляли больных животных.
В Англии, Финляндии, Швеции и др. странах противолейкозные мероприятия проводят по прин- ципу добровольных соглашений с владельцами животных. В нашей стране профилактика и борьба с лейкозом строится в соответствии с инструкцией по борьбе с лейкозом КРС.
Мероприятия по профилактике лейкоза предусматривают систематический контроль за клиническим состоянием животных, проведение серологических исследований на лейкоз взрослых животных один раз в год, охрану хозяйств от заноса инфекции.
С этой целью запрещено вводить (ввозить) животных в хозяйство, не проверенных на лейкоз серологическими методами. Вновь поступивших животных в период профилактического карантинирования подвергают серологическому исследованию.
Больных или серопозитивных животных возвращают поставщику или направляют на убой, а остальных животных через каждые 3 месяца исследуют на лейкоз одним из серологических методов до получения двух подряд отрицательных результатов. После этого их используют на общих основаниях.
Сперму, полученную от серо- позитивных быков-производите- лей, к использованию не допус- кают. Большое внимание уделяют соблюдению правил асептики и антисептики проведении ветеринарных и зоотехнических манипуляций с животными.
В неблагополучных хозяйствах предусматривают ряд ограничений, связанных: • с запрещением перемещений животных без разрешения ветспециалистов; • совместное содержание в одном родильном отделении серопозитивных к ВЛКРС животных; • использование для лечебных и профилактических целей нативной крови и сыворотки от больных и серопозитивных животных.
Больных животных изолируют, в течение 15 дней сдают на убой. Телят последнего отёла, полученных от таких коров, переводят в группы откорма.
Оздоровительные мероприятия осуществляют в зависимости от степени заражения животных ВЛКРС, принятой технологии, наличия животноводческих ферм и построек для содержания скота. В хозяйствах, где выявлено до 30% коров, зараженных ВЛКРС, оздоровление ведут путем разделения стада на группы:
серонегативных и серопозитивных животных размещают на отдельных фермах или скотных дворах. Серонегативных животных каждые три месяца исследуют серологическим методом до получения двух подряд отрицательных результатов по всей группе. Животных серопозитивных групп , с целью недопущения опухолевой формы, исследуют гематологическим методом с интервалом в 6 месяцев.
В хозяйстве, где выявляют более ЗО% серопозитивных животных и нет возможности проводить оздоровление методом разделения, все поголовье отно- сят к серопозитивной группе и исследуют гематологически 2 раза в год. Животных клинически больных лейкозом и клинически с изменениями крови, характерных для болезни, сдают на убой. болезни
Молоко от больных лейкозом коров Молоко кипятят 5 мин и используют на корм животных. Молоко животных, подозрительных по заболеванию, можно использовать в пищу людям после кипячения (5 мин) или постеризации (при 85 °С в течение 10 мин). Молоко здоровых коров благополучного стада используют на месте (после пастеризации) или сдают на молокозавод, где его используют после обычной пастеризации.

